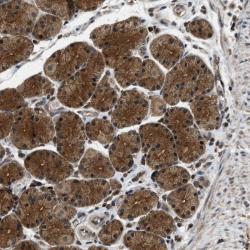

sc-230
antibody from Santa Cruz Biotechnology
Targeting: RPS6KB1
p70(S6K)-alpha, PS6K, S6K, S6K1, STK14A
Antibody data
- Antibody Data
- Antigen structure
- References [13]
- Comments [0]
- Validations
- Western blot [1]
- Immunohistochemistry [1]
Submit
Validation data
Reference
Comment
Report error
- Product number
- sc-230 - Provider product page

- Provider
- Santa Cruz Biotechnology
- Proper citation
- Santa Cruz Biotechnology Cat#sc-230, RRID:AB_632156
- Product name
- Anti-RPS6KB1
- Antibody type
- Polyclonal (Antigen purified)
- Antigen
- Synthetic peptide
- Reactivity
- Human
- Host
- Rabbit
Submitted references Identification and validation of novel spinophilin-associated proteins in rodent striatum using an enhanced ex vivo shotgun proteomics approach.
Induction of thyroid gene expression and radioiodine uptake in thyroid cancer cells by targeting major signaling pathways.
ARD1 stabilization of TSC2 suppresses tumorigenesis through the mTOR signaling pathway.
Nutrient withdrawal rescues growth factor-deprived cells from mTOR-dependent damage.
Polycystin-1 regulates extracellular signal-regulated kinase-dependent phosphorylation of tuberin to control cell size through mTOR and its downstream effectors S6K and 4EBP1.
TOR signaling is required for amino acid stimulation of early trypsin protein synthesis in the midgut of Aedes aegypti mosquitoes.
Reelin signals through phosphatidylinositol 3-kinase and Akt to control cortical development and through mTor to regulate dendritic growth.
HIF2 alpha reduces growth rate but promotes angiogenesis in a mouse model of neuroblastoma.
Neutrophils alter the inflammatory milieu by signal-dependent translation of constitutive messenger RNAs.
Overexpression of P70 S6 kinase protein is associated with increased risk of locoregional recurrence in node-negative premenopausal early breast cancer patients.
FKBP12-rapamycin-associated protein associates with mitochondria and senses osmotic stress via mitochondrial dysfunction.
FRAP/mTOR is required for proliferation and patterning during embryonic development in the mouse.
Ras signaling through PI3K confers hormone-independent proliferation that is compatible with differentiation
Baucum AJ 2nd, Jalan-Sakrikar N, Jiao Y, Gustin RM, Carmody LC, Tabb DL, Ham AJ, Colbran RJ
Molecular & cellular proteomics : MCP 2010 Jun;9(6):1243-59
Molecular & cellular proteomics : MCP 2010 Jun;9(6):1243-59
Induction of thyroid gene expression and radioiodine uptake in thyroid cancer cells by targeting major signaling pathways.
Hou P, Bojdani E, Xing M
The Journal of clinical endocrinology and metabolism 2010 Feb;95(2):820-8
The Journal of clinical endocrinology and metabolism 2010 Feb;95(2):820-8
ARD1 stabilization of TSC2 suppresses tumorigenesis through the mTOR signaling pathway.
Kuo HP, Lee DF, Chen CT, Liu M, Chou CK, Lee HJ, Du Y, Xie X, Wei Y, Xia W, Weihua Z, Yang JY, Yen CJ, Huang TH, Tan M, Xing G, Zhao Y, Lin CH, Tsai SF, Fidler IJ, Hung MC
Science signaling 2010 Feb 9;3(108):ra9
Science signaling 2010 Feb 9;3(108):ra9
Nutrient withdrawal rescues growth factor-deprived cells from mTOR-dependent damage.
Panieri E, Toietta G, Mele M, Labate V, Ranieri SC, Fusco S, Tesori V, Antonini A, Maulucci G, De Spirito M, Galeotti T, Pani G
Aging 2010 Aug;2(8):487-503
Aging 2010 Aug;2(8):487-503
Polycystin-1 regulates extracellular signal-regulated kinase-dependent phosphorylation of tuberin to control cell size through mTOR and its downstream effectors S6K and 4EBP1.
Distefano G, Boca M, Rowe I, Wodarczyk C, Ma L, Piontek KB, Germino GG, Pandolfi PP, Boletta A
Molecular and cellular biology 2009 May;29(9):2359-71
Molecular and cellular biology 2009 May;29(9):2359-71
TOR signaling is required for amino acid stimulation of early trypsin protein synthesis in the midgut of Aedes aegypti mosquitoes.
Brandon MC, Pennington JE, Isoe J, Zamora J, Schillinger AS, Miesfeld RL
Insect biochemistry and molecular biology 2008 Oct;38(10):916-22
Insect biochemistry and molecular biology 2008 Oct;38(10):916-22
Reelin signals through phosphatidylinositol 3-kinase and Akt to control cortical development and through mTor to regulate dendritic growth.
Jossin Y, Goffinet AM
Molecular and cellular biology 2007 Oct;27(20):7113-24
Molecular and cellular biology 2007 Oct;27(20):7113-24
HIF2 alpha reduces growth rate but promotes angiogenesis in a mouse model of neuroblastoma.
Favier J, Lapointe S, Maliba R, Sirois MG
BMC cancer 2007 Jul 26;7:139
BMC cancer 2007 Jul 26;7:139
Neutrophils alter the inflammatory milieu by signal-dependent translation of constitutive messenger RNAs.
Lindemann SW, Yost CC, Denis MM, McIntyre TM, Weyrich AS, Zimmerman GA
Proceedings of the National Academy of Sciences of the United States of America 2004 May 4;101(18):7076-81
Proceedings of the National Academy of Sciences of the United States of America 2004 May 4;101(18):7076-81
Overexpression of P70 S6 kinase protein is associated with increased risk of locoregional recurrence in node-negative premenopausal early breast cancer patients.
van der Hage JA, van den Broek LJ, Legrand C, Clahsen PC, Bosch CJ, Robanus-Maandag EC, van de Velde CJ, van de Vijver MJ
British journal of cancer 2004 Apr 19;90(8):1543-50
British journal of cancer 2004 Apr 19;90(8):1543-50
FKBP12-rapamycin-associated protein associates with mitochondria and senses osmotic stress via mitochondrial dysfunction.
Desai BN, Myers BR, Schreiber SL
Proceedings of the National Academy of Sciences of the United States of America 2002 Apr 2;99(7):4319-24
Proceedings of the National Academy of Sciences of the United States of America 2002 Apr 2;99(7):4319-24
FRAP/mTOR is required for proliferation and patterning during embryonic development in the mouse.
Hentges KE, Sirry B, Gingeras AC, Sarbassov D, Sonenberg N, Sabatini D, Peterson AS
Proceedings of the National Academy of Sciences of the United States of America 2001 Nov 20;98(24):13796-801
Proceedings of the National Academy of Sciences of the United States of America 2001 Nov 20;98(24):13796-801
Ras signaling through PI3K confers hormone-independent proliferation that is compatible with differentiation
Lisa A Cass, Judy L Meinkoth
Oncogene 2000 Mar;19(7):924-932
Oncogene 2000 Mar;19(7):924-932
No comments: Submit comment
Supportive validation
- Submitted by
- per
- Main image

- Experimental details
- Western blot analysis of antibody specificity using a routine panel composed of IgG/HSA-depleted human plasma and protein lysates from selected human tissues and cell lines.
- Validation comment
- Single band corresponding to the predicted size in kDa (+/-20%).
- Primary Ab dilution
- 1:500
- Secondary Ab dilution
- 1:3000
- Lane 1
- Marker [kDa]: 250, 130, 95, 72, 55, 36, 28, 17, 11
- Lane 2
- RT-4
- Lane 3
- U-251MG sp
- Lane 4
- Human Plasma
- Lane 5
- Liver
- Lane 6
- Tonsil
- Theoretical target weight
- [kDa] 51
Supportive validation
- Submitted by
- per
- Main image
- Experimental details
- Immunohistochemical staining of human stomach shows cytoplasmic positivity in glandular cells.
- Validation comment
- Staining pattern partly consistent with experimental and/or bioinformatic data.